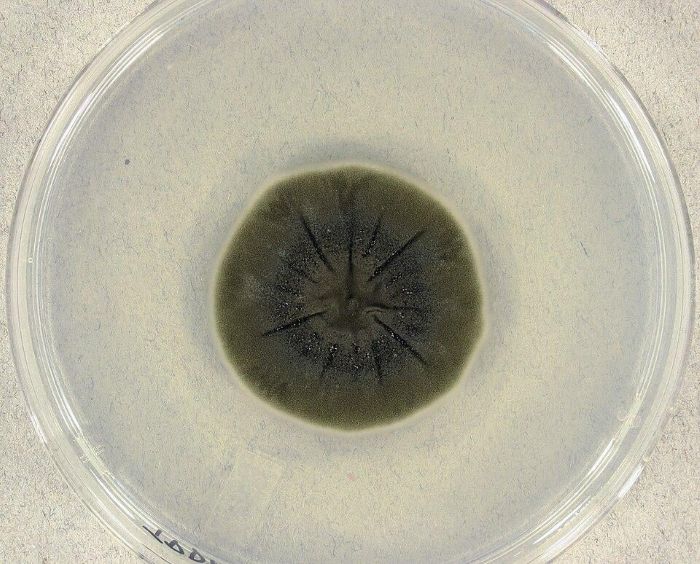

Kaip pažymėjo leidinys „Іnteresting engineering“, mokslininkai išsiaiškino, kad savotiškas tamsiai juodas grybas, augantis Černobylio katastrofos vietoje, išgyvena maitindamasis mirtina radiacija.
1997 m. ukrainiečių mikologė Nelė Ždanova aptiko juodą pelėsį, apgyvendinusį labai radioaktyvias Černobylio atominės elektrinės griuvėsius. Grybas augo ant sienų, lubų ir net reaktoriaus pastato viduje, nepaisant itin aukšto radioaktyvumo lygio.
Tyrimas parodė, kad grybai ypatingu būdu sąveikauja su spinduliuote.
„Tai išskirtinis atradimas, kuris parodė, kad gyvybė gali klestėti ir augti esant radiacijai. Jis sukėlė abejonių dėl nusistovėjusių sampratų apie gyvybės atsparumą.
Be to, jis atvėrė galimybes naudoti šį pelėsį tokiose srityse kaip radioaktyvių objektų valymas ir astronautų apsauga nuo kosminės spinduliuotės kosmose“, – teigiama straipsnyje.
Taip pat ten teigiama, kad spinduliuotės apsaugos ir sugėrimo funkciją perėmė melaninas – tas pats pigmentas, kuris suteikia spalvą žmogaus odai ir apsaugo nuo ultravioletinių spindulių.
2007 m. tyrimas atskleidė svarbų atradimą: melanizuoti grybai augo 10 proc. greičiau, veikiami radioaktyvaus cezio, o tai rodo, kad jie aktyviai naudojo spinduliuotę metabolinei energijai gauti.
Šis procesas buvo pavadintas radiacinė sintezė.
C. sphaerospermum rūšies grybai tiesiog maitinasi radiacija / nuotrauka Vikipedija
Tačiau tolesni tyrimai parodė, kad ne visi melanizuoti grybai elgiasi taip.
Tarptautinė mokslo bendruomenė nusiuntė Cladosporium sphaerospermum pavyzdžius – tą pačią rūšį, kuri buvo rasta Černobilyje – į Tarptautinę kosminę stotį (TKS).
Tai, kas įvyko toliau, patvirtino pelėsių kosminį potencialą. Intensyvios kosminės spinduliuotės sąlygomis grybai klestėjo, demonstruodami 1,21 karto didesnį augimo greitį nei kontroliniai pavyzdžiai Žemėje.
Eksperimentas ISS taip pat parodė pelėsių potencialą kaip apsauginės barjeros. Augdami grybai ekranavo didelį spinduliuotės kiekį, palyginti su kontrolinėmis zonomis.
Papildoma apsauga nuo radiacijos
Remdamiesi šiais eksperimentais, ekspertai daro prielaidą, kad numanomos pelėsių radiacinės apsaugos savybės gali būti susijusios ne tik su melaninu, bet ir su kitais biologiniais komponentais, pvz., vandeniu.
Straipsnyje pažymima, kad galaktinė kosminė spinduliuotė, greitai judantys įkrauti protonai iš sprogstančių žvaigždžių, yra „didžiausias pavojus“ astronautams, išvykstantiems už Žemės apsauginės atmosferos ribų.
O standartiniai apsaugos sprendimai, tokie kaip sunkieji metalai, yra brangūs ir sunkūs paleisti į kosmosą. Tuo tarpu Černobylio grybelio forma siūlo paprastą biologinę alternatyvą.
NASA astrobiologė Lynn J. Rothschild siūlo „mikroarchitektūrą“ – iš grybų Mėnulyje ar Marse išaugintas gyvenamąsias aplinkas.
Šios gyvos sienos bus ne tik struktūrinės: jos bus savaime atsinaujinančios radiacijos ekranai, o tai žymiai sumažins paleidimo išlaidas.
Kolonizavę toksišką vietą, tokią kaip Černobylis, šie grybai galiausiai gali apsaugoti astronautus artimiausioje ateityje.



































Rašyti komentarą